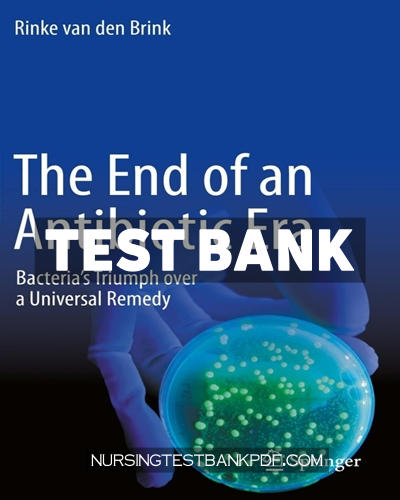

Test Bank for The Historical Roots of Human Trafficking by Springer
$60.00 Original price was: $60.00.$29.00Current price is: $29.00.
Test Bank for Precision Medicine in Stroke by Springer
$60.00 Original price was: $60.00.$29.00Current price is: $29.00.
Test Bank for The End of an Antibiotic Era by van den Brink
$60.00 Original price was: $60.00.$29.00Current price is: $29.00.
Complete test bank for the end of an antibiotic era by van den brink. All chapters are included. Instant download.
[su_expand more_text="Download Sample" height="0" hide_less="yes" link_style="button" link_color="#4eba00" more_icon="icon: tag"][su_highlight] [/su_highlight][/su_expand]
SKU:
9783030707231-TEST-BANK
Category: Springer Test Banks
Description
Downloadable test bank for the end of an antibiotic era by van den brink. All chapters are included. Instant download.
iSBN: 9783030707224,9783030707231.
Shipping & Delivery